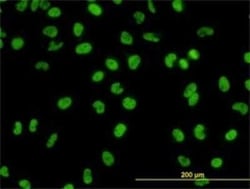
GATA-2 Antibody (2D11), Novus Biologicals 0.1 mg, Unconjugated:Antibodies,

missing translation for 'onlineSavingsMsg'
Learn More
Learn More
GATA-2 Antibody (2D11), Novus Biologicals™
Mouse Monoclonal Antibody
Brand: Novus Biologicals H00002624-M01
This item is not returnable.
View return policy
Description
GATA-2 Monoclonal antibody specifically detects GATA-2 in Human samples. It is validated for Western Blot, Flow Cytometry, ELISA, Immunocytochemistry/ Immunofluorescence, KnockDown
Specifications
| GATA-2 | |
| Monoclonal | |
| Unconjugated | |
| In 1x PBS, pH 7.4 | |
| endothelial transcription factor GATA-2, FLJ45948, GATA binding protein 2, GATA-binding protein 2NFE1B, MGC2306 | |
| GATA2 (AAH18988, 1 a.a. ~ 102 a.a) partial recombinant protein with GST tag. MW of the GST tag alone is 26 KDa. MEVAPEQPRWMAHPAVLNAQHPDSHHPGLAHNYMEPAQLLPPDEVDVFFNHLDSQGNPYYANPAHARARVSYSPAHARLTGGQMCRPHLLHSPGLPWLDGGK | |
| 0.1 mg | |
| Cardiovascular Biology, Cell Biology, Stem Cells | |
| 2624 | |
| Aliquot and store at -20°C or -80°C. Avoid freeze-thaw cycles. | |
| IgG2a κ |
| Western Blot, Flow Cytometry, ELISA, Immunocytochemistry, KnockDown | |
| 2D11 | |
| Western Blot 1:500, Flow Cytometry, ELISA, Immunocytochemistry/ Immunofluorescence, Knockdown Validated | |
| AAH18988 | |
| Mouse | |
| IgG purified | |
| RUO | |
| Primary | |
| Human | |
| Purified |
Product Content Correction
Your input is important to us. Please complete this form to provide feedback related to the content on this product.
Product Title
Spot an opportunity for improvement?Share a Content Correction